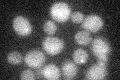
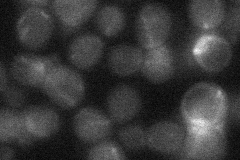
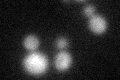
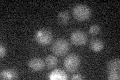

View description
Large subunit of the dynactin complex, which is involved in partitioning the mitotic spindle between mother and daughter cells; putative ortholog of mammalian p150(glued)
Localization:
Intensity:
Fold change:
Significance:
-
C’ GFP library in SD
below threshold17.78 -
N' NOP1pr-GFP in SD

cytosol,punctate46.6594 -
N' TEF2pr-mCherry in SD

punctate15.7813 -
N' NATIVEpr-GFP in SD
punctate20.6686 -
N' TEF2pr-VC and Cyto-VN in SD

below threshold26.7333 -
C’ GFP library in SD+DTT
cytosol17.781No -
C’ GFP library in SD+H2O2

cytosol17.720.99No -
C’ GFP library in Starvation Media
cytosol15.720.88No -
C’ GFP library on the background of Pup2-DaMP

N/A -
C’ GFP library on the background of CCT mutant

N/A0N/AYes
